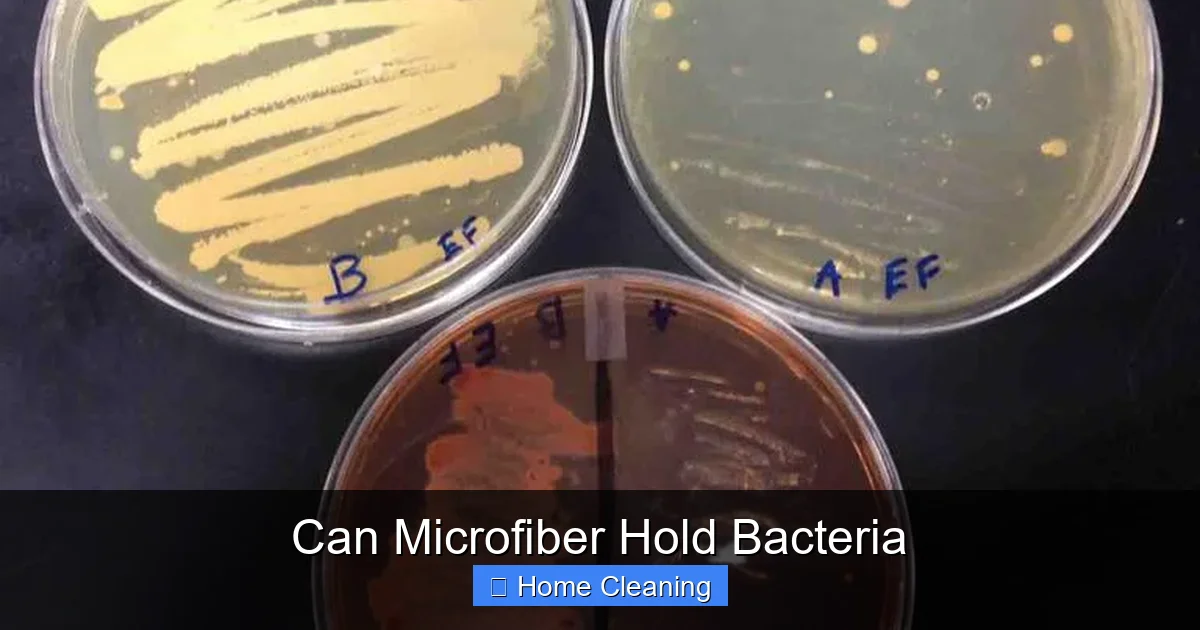
Can Microfiber Hold Bacteria

Can Microfiber Hold Bacteria
Can microfiber hold bacteria? Yes, but it doesn’t necessarily mean it’s dirty or unsafe. Microfiber’s tiny fibers create a physical barrier that traps dust, dirt, and microbes. However, if not cleaned properly, bacteria can multiply on or inside the fibers. With proper care, microfiber can be a powerful tool for reducing germs in your home.
Key Takeaways
- Microfiber traps bacteria physically: Its dense, split fibers create a large surface area that captures and holds tiny particles, including bacteria.
- Proper cleaning prevents bacterial growth: If microfiber isn’t washed regularly, trapped bacteria can multiply, defeating its cleaning purpose.
- Hot water and detergent kill germs: Washing microfiber in hot water (at least 140°F) with regular detergent effectively removes and kills bacteria.
- Microfiber doesn’t spread bacteria: Unlike traditional cloths, microfiber rarely redistributes germs due to its electrostatic charge and tight weave.
- Use separate cloths for different areas: Prevent cross-contamination by using dedicated microfiber cloths for kitchens, bathrooms, and living spaces.
- Air-drying preserves effectiveness: High heat from dryers can damage microfiber; air-drying helps maintain its cleaning power and extends lifespan.
- Microfiber is eco-friendly and efficient: When used and cleaned correctly, microfiber reduces the need for chemical cleaners and disposable wipes.
📑 Table of Contents
- Can Microfiber Hold Bacteria? The Science Behind Microfiber Cleaning
- The Structure of Microfiber: Why It’s So Effective at Trapping Particles
- Can Microfiber Actually Hold Bacteria?
- Does Microfiber Spread Bacteria?
- How to Clean Microfiber to Kill Bacteria
- Can Microfiber Replace Disposable Wipes?
- Microfiber in Professional Cleaning: What Experts Say
- Common Myths About Microfiber and Bacteria
- Final Thoughts: Is Microfiber Safe to Use?
Can Microfiber Hold Bacteria? The Science Behind Microfiber Cleaning
Have you ever reached for a microfiber cloth to wipe down your kitchen counter or clean your bathroom mirror, only to wonder: Can microfiber hold bacteria? It’s a smart question—especially if you’re concerned about germs in your home. Microfiber has become a go-to cleaning tool for many households and professional cleaners alike, praised for its ability to trap dirt and dust with minimal effort. But beneath its soft, lint-free surface lies a complex world of tiny fibers and electrostatic charges that interact with microscopic life forms like bacteria.
Understanding how microfiber works—and whether it can hold bacteria—requires a closer look at its structure and function. Microfiber is made from ultra-fine synthetic fibers, typically polyester and polyamide, that are split into even finer strands. These fibers are incredibly small, measuring just a few microns in diameter. This minuscule size, combined with a high surface area, allows microfiber to attract and hold particles—including bacteria—through a combination of mechanical trapping and electrostatic attraction. But does this mean microfiber is a germ magnet? The answer isn’t a simple yes or no. It depends on how the cloth is used, washed, and maintained.
The Structure of Microfiber: Why It’s So Effective at Trapping Particles
The Science of Split Fibers
Microfiber’s cleaning power comes from its unique fiber structure. Unlike regular cotton cloths, which have smooth, continuous fibers, microfiber fibers are split into multiple strands. This splitting process increases the surface area dramatically, allowing the cloth to hold more dirt, dust, and moisture. In fact, a single microfiber strand can be up to 100 times thinner than a human hair. This fine texture means that when you wipe a surface, the fibers physically entrap particles rather than just pushing them around.

Visual guide about Can Microfiber Hold Bacteria
Image source: york.pl
But mechanical trapping isn’t the only trick up microfiber’s sleeve. These fibers also generate an electrostatic charge when agitated—like when you rub them against a surface. This static electricity helps attract and hold even smaller particles, including bacteria, which are typically less than 5 microns in size. Think of it like a magnet for dirt: the cloth doesn’t just pick up visible grime—it captures microscopic invaders too.
How Microfiber Differs from Regular Cleaning Cloths
Regular cotton or terry cloths work differently. They absorb liquids and can spread bacteria around as you wipe. If a cotton cloth picks up germs from a kitchen counter, it may transfer them to your sink, stove, or even your hands. Microfiber, on the other hand, doesn’t absorb liquids as readily. Instead, it holds moisture in the tiny spaces between fibers. This means it can clean without spreading germs—especially if you use it dry for dusting or with a damp cloth for wet cleaning.
Another key difference is lint production. Cotton cloths shed fibers and lint, which can carry bacteria and irritants. Microfiber, by contrast, is lint-free and doesn’t leave behind residue. This makes it ideal for cleaning sensitive surfaces like eyeglasses, electronics, and stainless steel appliances—where you don’t want streaks or particles left behind.
Can Microfiber Actually Hold Bacteria?
The Physical Trapping Mechanism
Yes, microfiber can hold bacteria. The fibers’ tiny gaps act like a net, catching bacteria and other microorganisms as you wipe. Studies have shown that high-quality microfiber cloths can capture up to 99% of bacteria from surfaces when used properly. This includes common germs like E. coli, Staphylococcus aureus, and Salmonella.
Visual guide about Can Microfiber Hold Bacteria
Image source: scienceprofonline.com
But here’s the catch: holding bacteria doesn’t mean the cloth is harmless. If the microfiber isn’t cleaned after use, those trapped bacteria can multiply inside the fibers. Think of it like a petri dish—warm, moist, and dark. That’s exactly the environment bacteria love. So while microfiber can capture germs, it can also become a breeding ground if not cared for.
Microfiber vs. Other Cleaning Materials
Compared to paper towels or sponges, microfiber is far more effective at trapping bacteria. Paper towels are disposable, so they don’t hold germs long-term, but they’re also less efficient at cleaning. Sponges, on the other hand, absorb liquids and often harbor bacteria in their porous structure. They’re notorious for spreading germs if not sanitized regularly.
Microfiber strikes a balance. It doesn’t absorb as much liquid as a sponge, reducing the risk of bacterial growth. And because it’s reusable, it’s more eco-friendly than disposable options. But again—reusability comes with responsibility. You can’t just use a microfiber cloth once and toss it in the laundry basket without a second thought.
Does Microfiber Spread Bacteria?
The Risk of Cross-Contamination
This is a common concern: if microfiber holds bacteria, does it spread them as you wipe? The answer depends on how you use the cloth. If you use the same microfiber cloth to clean the bathroom sink and then the kitchen counter, you risk spreading germs from one area to another. That’s why many experts recommend using separate microfiber cloths for different rooms or tasks.

Visual guide about Can Microfiber Hold Bacteria
Image source: melaminefoamew.com
However, unlike cotton towels, microfiber rarely redistributes germs. Its electrostatic charge and tight weave mean that once bacteria are trapped, they’re less likely to be released back into the air or onto other surfaces—especially if you’re using the cloth dry. Wet cleaning can increase the risk of spreading, so it’s best to use clean, damp microfiber for wet tasks and dry microfiber for dusting.
Best Practices to Prevent Germ Spread
- Use a separate microfiber cloth for bathrooms and kitchens.
- Label cloths by room to avoid cross-contamination.
- Wash microfiber after every few uses, not just when visibly dirty.
- Never share microfiber cloths with others in the household.
How to Clean Microfiber to Kill Bacteria
Washing Microfiber Cloths
To keep your microfiber clean and hygienic, you need to wash it regularly. Most experts recommend washing microfiber after every 3–5 uses, depending on how heavily it’s used. Don’t wait until the cloth is visibly dirty—bacteria multiply fast, even under the surface.
Use warm or hot water (at least 140°F) and a mild detergent. Avoid fabric softeners and dryer sheets, as they coat the fibers and reduce their effectiveness. Fabric softeners can clog the tiny pores in microfiber, making it less able to trap dirt and bacteria. Instead, opt for a gentle, enzyme-free detergent.
Air-Drying vs. Machine Drying
After washing, air-drying is the best option. High heat from dryers can melt or damage the microfiber fibers, reducing their cleaning power. If you must use a dryer, use the lowest heat setting and remove the cloth while it’s still slightly damp. Never put microfiber in the dryer with zippers, buttons, or other rough fabrics, as they can snag and damage the fibers.
Deep Cleaning Tips
- Wash microfiber separately from other laundry to avoid lint transfer.
- Add a cup of white vinegar to the rinse cycle to help remove residue and kill odor-causing bacteria.
- For heavily soiled cloths, pre-soak in warm water with a bit of baking soda before washing.
Can Microfiber Replace Disposable Wipes?
Environmental and Cost Benefits
Yes, microfiber can replace disposable wipes in many cleaning tasks—and it’s better for the environment. Disposable wipes contribute to landfill waste and often contain chemicals that can harm aquatic life. Microfiber, on the other hand, is reusable and lasts for hundreds of washes when cared for properly.
From a cost perspective, microfiber pays for itself over time. A single microfiber cloth can replace dozens of disposable wipes. Plus, you can use it with just water for dusting or with a small amount of cleaning solution for tougher jobs—reducing the need for chemical cleaners.
Limitations of Microfiber
However, microfiber isn’t perfect. It can’t handle all types of messes. For example, it’s not ideal for cleaning up large spills of sticky liquids or hazardous materials. In those cases, disposable wipes or paper towels may be safer and more practical. Also, microfiber doesn’t disinfect surfaces—it only cleans and traps germs. For true disinfection, you’ll still need an EPA-approved disinfectant.
Microfiber in Professional Cleaning: What Experts Say
Hospitals and Laboratories
In hospitals and labs, microfiber is widely used because of its ability to capture bacteria without spreading them. Studies have shown that microfiber mops and cloths reduce surface contamination by up to 99% compared to traditional mops. This is why many healthcare facilities rely on microfiber for routine cleaning.
Commercial Kitchens
Restaurants and commercial kitchens use microfiber for food prep areas because it doesn’t harbor bacteria in porous surfaces. A clean microfiber cloth can safely wipe down cutting boards and countertops without risking cross-contamination.
Households
For home use, microfiber is a smart choice—but only if you follow proper hygiene practices. Keep a set of cloths for different areas, wash them regularly, and avoid overloading them with water or cleaning products.
Common Myths About Microfiber and Bacteria
Myth: Microfiber Spreads More Germs Than Cotton
False. While microfiber can hold bacteria, it doesn’t spread them like cotton towels. Cotton absorbs liquids and can transfer germs from one surface to another. Microfiber, with its electrostatic charge and non-absorbent nature, is actually better at trapping germs in place.
Myth: You Need Special Detergent to Clean Microfiber
Not necessarily. Regular laundry detergent works fine. Just avoid fabric softeners and bleach, which can damage the fibers. A mild, enzyme-free detergent is ideal.
Myth: Microfiber Only Works with Water
While microfiber works great with just water, it can also be used with cleaning solutions. Just use a small amount—too much liquid can reduce its effectiveness.
Final Thoughts: Is Microfiber Safe to Use?
Yes, microfiber is safe to use—when you use it correctly. It’s a powerful cleaning tool that can trap bacteria, reduce the need for chemicals, and last for years with proper care. The key is understanding how it works and treating it like a reusable tool, not a disposable one.
By washing microfiber regularly, using separate cloths for different areas, and avoiding common mistakes like fabric softeners, you can keep your home cleaner and safer. Microfiber isn’t a magic solution—but it’s one of the most effective tools you can have in your cleaning arsenal.
So the next time you reach for a microfiber cloth, remember: it’s not just about wiping away dirt. It’s about trapping germs, reducing waste, and keeping your home healthier—one wipe at a time.
Frequently Asked Questions
Can microfiber cloths hold bacteria?
Yes, microfiber cloths can physically trap bacteria due to their dense, split fibers and electrostatic charge. However, they don’t absorb liquids like cotton, so they hold germs in place rather than spreading them.
How do you clean microfiber to kill bacteria?
Wash microfiber in hot water (at least 140°F) with mild detergent, avoiding fabric softeners. Air-dry to preserve fiber integrity. For extra hygiene, add a cup of white vinegar to the rinse cycle.
Can you use microfiber to disinfect surfaces?
Microfiber cleans and traps bacteria but does not disinfect. For true disinfection, use an EPA-approved disinfectant after cleaning with microfiber.
Do microfiber cloths spread bacteria?
Microfiber rarely spreads bacteria because it traps germs in its fibers. However, using the same cloth in multiple areas can cause cross-contamination, so separate cloths by room are recommended.
How often should you wash microfiber?
Wash microfiber after every 3–5 uses, depending on how heavily it’s used. Don’t wait until it looks dirty—bacteria multiply quickly, even under the surface.
Can you use fabric softener on microfiber?
No, fabric softeners coat microfiber fibers and reduce their cleaning power by clogging the tiny pores. Use only mild, enzyme-free detergents instead.






